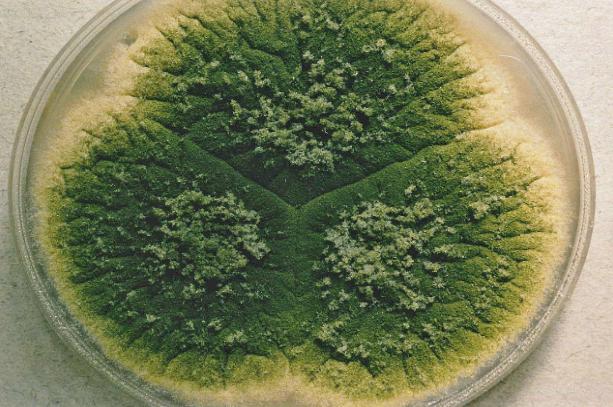

Beberapa jenis jamur seperti Aspergillus flavus dan Aspergillus parasiticus dapat menghasilkan toksin atau racun yang disebut sebagai AFLATOKSIN. Sebuah racun yang dapat memicu dampak sangat merugikan tubuh kita bila terpapar dalam jumlah besar (sedikit pun juga berbahaya ges sebenarnya).
Gambar 1. Foto mikroskop elektron (SEM) dari Aspergillus flavus (Researchgate)
Kedua jenis jamur tersebut penghasil AFLATOKSIN bisa tumbuh di berbagai jenis makanan seperti biji-bijian, jagung, kedelai, dll yang terkontaminasi. Akan sangat berbahaya jika makanan tersebut sampai tertelan atau masuk ke dalam tubuh ketika kita melakukan aktivitas makan atau minum.
Gambar 2. Macam-macam racun aflatoxin yang telah teridentifikasi (ScienceDirect)
Jenis racun ini sangat berbahaya bagi manusia karena bisa memicu terbentuknya kanker hati atau hepatocelluler carcinoma (HCC), kondisi ini memungkinkan sel hati atau hepatosit mengalami proliferasi atau perbanyakan diri yang tidak terkendali. Hal tersebut akan mengganggu fungsi organ hati, kanker hati juga salah satu penyebab kematian tertinggi. Meskipun demikian penelitian tentang obat kanker hati sampai saat ini terus dilakukan dan dikembangkan untuk meningkatkan efek terapi pada pasien.
Gambar 3. Foto SEM sel kanker hati (Science Photo Gallery)
AFLATOKSIN bisa bersifat reaktif di dalam sel kita yaitu dengan bereaksi pada sitokrom P450 dalam hati. Nah sitokrom ini merupakan suatu jenis protein yang mana kinerjanya dapat menjadi kofaktor (pemicu peningkatan) aktivitas enzim tertentu dengan cara berikatan dan membentuk kompleks molekul.
Akibat reaksi tersebut memicu pembentukan Aflatoxin-8,9-epoxide atau AFBO menjadi penyebab mutasi pada DNA hingga kanker.
Tanya-tanya? DM ke IG @violthebiologist
Penulis
Viol Dhea Kharisma, S.Si., M.Si
(Content Creator & Peneliti Biologi)
Follow Instagram @violthebiologist
Follow Facebook Viol The Biologist
Follow TikTok @violthescientist
Bahan Bacaan:
Marchese S, Polo A, Ariano A, Velotto S, Costantini S, Severino L. Aflatoxin B1 and M1: Biological Properties and Their Involvement in Cancer Development. Toxins (Basel). 2018 May 24;10(6):214. doi: 10.3390/toxins10060214.
Magnussen A, Parsi MA. Aflatoxins, hepatocellular carcinoma and public health. World J Gastroenterol. 2013 Mar 14;19(10):1508-12. doi: 10.3748/wjg.v19.i10.1508.

%20dari%20Aspergillus%20flavus.jpg)


